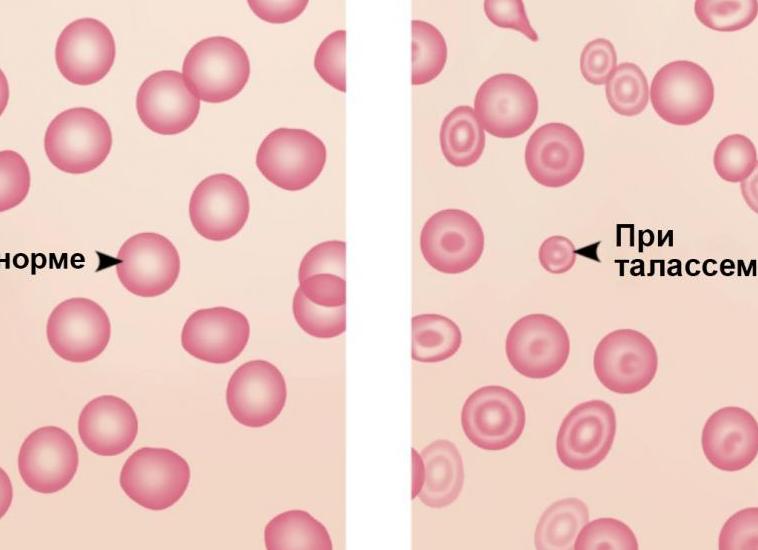
Мишеневидные эритроциты определяются при заболевании

Мно анализ крови расшифровка у взрослых норма в таблице

анализ крови мно расшифровка у взрослых норма в таблице
Анализ крови на МНО: норма показателя у мужчин и женщин, расшифровка результатов
Мало кто из простых обывателей знает расшифровку аббревиатуры МНО. А ведь эти три буквы представляют собой наиболее точный метод оценки работы свертывающей системы крови. Нормы других показателей системы свертывания (протромбина, фибриногена, времени свертывания и времени кровотечения) варьируются в зависимости от пола, возраста, лаборатории, в которой проводилось исследование, используемого реактива. Но анализ крови на МНО — признанный во всем мире показатель, единственный для всех лабораторий.